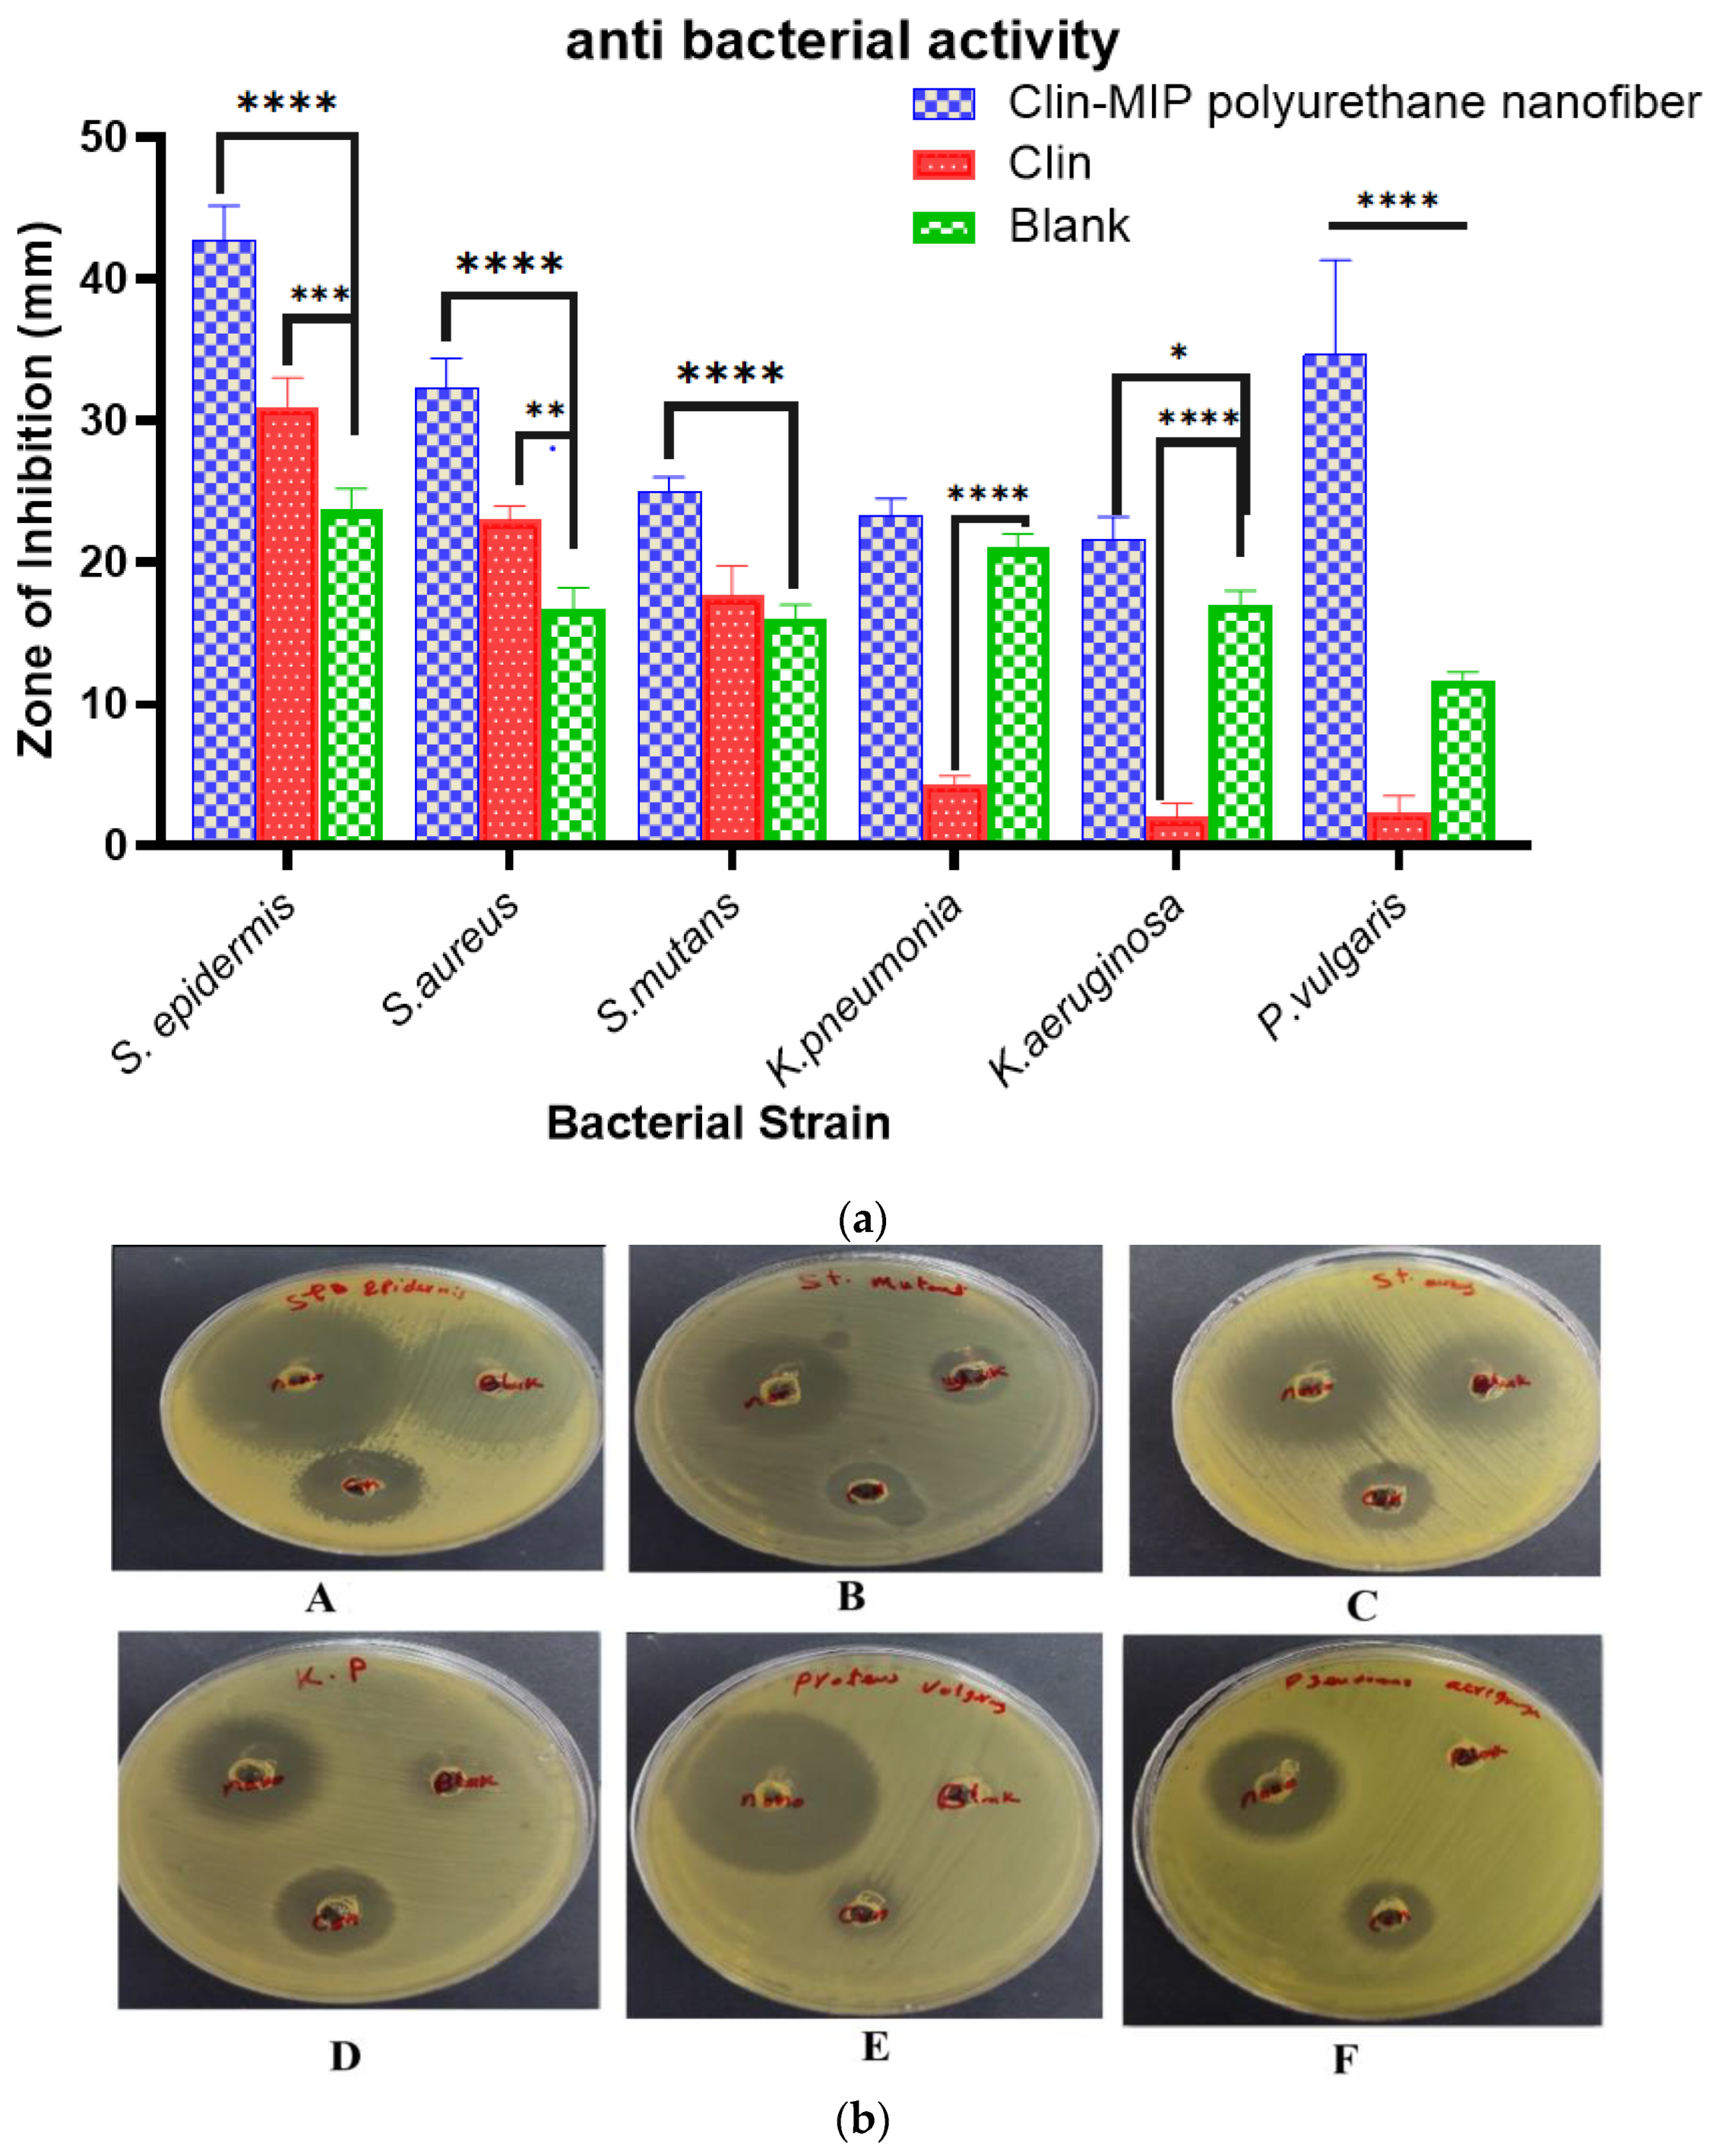

Enhanced Antibacterial Activity of Clindamycin Using Molecularly Imprinted Polymer Nanoparticles Loaded with Polyurethane Nanofibrous Scaffolds for the Treatment of Acne Vulgaris
Abstract
1. Introduction
2. Materials and Methods
2.1. Materials
2.2. Animals
2.3. Methods
2.3.1. Synthesis of the Clindamycin Molecularly Imprinted Polymer (Clin-MIP)
2.3.2. In-Vitro Characterization of Clindamycin Molecularly Imprinted Polymer (Clin-MIP)
Particle Size and Transmission Electron Microscopy (TEM)
Fourier Transformer Infrared Spectroscopy (FTIR)
Discussion of Differential Scanning Calorimetry (DSC) Analysis
Binding Studies
- Static Equilibrium Adsorption Experiments
- Kinetic Adsorption Study
2.3.3. Fabrication of Composite Polyurethane Nanofiber Dressings by Electrospinning
2.3.4. In-Vitro Characterization of Clin-MIP Polyurethane Nanofiber (CMPN)
Consistency in Thickness and Weight
Evaluation of Flexibility and Strength
Fourier-Transform Infrared Spectroscopy (FTIR)
Morphology Characterization
Assessment of In-Vitro Drug Release
2.4. Ex Vivo Skin Permeation Study
2.5. In Vitro Cell Toxicity Assessment
2.6. Determination of Antimicrobial Activity
2.6.1. Agar Well Diffusion Assay
2.6.2. Bacterial Proliferation Inhibition Analysis
2.6.3. Bacterial Killing Kinetic Assay
2.7. In-Vivo Study
2.8. In Vivo Evaluation of the Prepared Clin-MIP Polyurethane Nanofiber (CMPN)
2.8.1. Induction of an Inflammatory Acne Model Using the Viable Count of Infected Rat Skin
2.8.2. Assessment of Inflammatory Biomarkers
2.9. Histopathological Examination
Assessment of Ear Thickness and Anti-Inflammatory Potential on the Skin’s Surface
3. Results and Discussion
3.1. Synthesis of Clindamycin Molecularly Imprinted Polymers
3.2. In-Vitro Characterization of Clindamycin Molecularly Imprinted Polymer (Clin-MIP)
3.2.1. Particle Size and Transmission Electron Microscopy (TEM)
3.2.2. Fourier Transformer Infrared Spectroscopy (FTIR)
3.2.3. Discussion of Differential Scanning Calorimetry (DSC) Analysis
3.2.4. Binding Studies
Imprinting Efficacy and Selectivity
Adsorption Kinetics
3.3. Fabrication of Composite Polyurethane Nanofiber Dressings by Electrospinning
3.4. In-Vitro Characterization of Clin-MIP Polyurethane Nanofiber (CMPN)
3.4.1. Thickness and Weight Uniformity
3.4.2. Flexibility and Strength Testing Pieces of Nanofiber
3.4.3. Morphology Characterization of Clin-MIP Polyurethane Nanofiber
3.5. In-Vitro Drug Release
3.6. Ex-Vivo Skin Permeation Study
3.7. In Vitro Cell Toxicity
3.8. Determination of Antimicrobial Activity
3.8.1. Antimicrobial Activity of Drug Formulation
3.8.2. Anti-Proliferation Activity of Clin. Nano Formula
3.8.3. Bacterial Killing Kinetic Assay
3.9. In Vivo Study
3.9.1. Assessment of Ear Thickness and Anti-Inflammatory Potential
3.9.2. Healing Activities of Clin-MIP Polyurethane Nanofiber Using the Viable Count Method in an Animal Model
3.9.3. Assessment of Inflammatory Biomarkers
3.10. Histopathological Examination
4. Conclusions
Author Contributions
Funding
Institutional Review Board Statement
Informed Consent Statement
Data Availability Statement
Conflicts of Interest
References
- Elhabal, S.F.; Abdelaal, N.; Al-Zuhairy, S.A.S.; Mohamed Elrefai, M.F.; Khalifa, M.M.; Khasawneh, M.A.; Elsaid Hamdan, A.M.; Mohie, P.M.; Gad, R.A.; Kabil, S.L.; et al. Revolutionizing Psoriasis Topical Treatment: Enhanced Efficacy through Ceramide/Phospholipid Composite Cerosomes Co-Delivery of Cyclosporine and Dithranol: In-Vitro, Ex-Vivo, and in-Vivo Studies. Int. J. Nanomed. 2024, 19, 1163–1187. [Google Scholar] [CrossRef] [PubMed]
- Elhabal, S.; Abdelaal, N.; Saeed Al-Zuhairy, S.; Elrefai, M.; Elsaid Hamdan, A.; Khalifa, M.; Hababeh, S.; Khasawneh, M.; Khamis, G.; Nelson, J.; et al. Green Synthesis of Zinc Oxide Nanoparticles from Althaea officinalis Flower Extract Coated with Chitosan for Potential Healing Effects on Diabetic Wounds by Inhibiting TNF-α and IL-6/IL-1β Signaling Pathways. Int. J. Nanomed. 2024, 19, 3045–3070. [Google Scholar] [CrossRef] [PubMed]
- Jain, A.; Garg, N.K.; Jain, A.; Kesharwani, P.; Jain, A.K.; Nirbhavane, P.; Tyagi, R.K. A Synergistic Approach of Adapalene-Loaded Nanostructured Lipid Carriers, and Vitamin C Co-Administration for Treating Acne. Drug Dev. Ind. Pharm. 2016, 42, 897–905. [Google Scholar] [CrossRef]
- Wu, J.; Guo, R.; Chai, J.; Xiong, W.; Tian, M.; Lu, W.; Xu, X. The Protective Effects of Cath-MH With Anti-Propionibacterium Acnes and Anti-Inflammation Functions on Acne Vulgaris. Front. Pharmacol. 2021, 12, 788358. [Google Scholar] [CrossRef]
- Rottboell, L.; De Foenss, S.; Thomsen, K.; Christiansen, H.; Andersen, S.M.; Dam, T.N.; Rosada, C.; Stenderup, K. Exploring Valrubicin’s Effect on Propionibacterium Acnes-Induced Skin Inflammation in Vitro and in Vivo. Dermatol. Rep. 2015, 7, 39–43. [Google Scholar] [CrossRef]
- Armillei, M.K.; Lomakin, I.B.; Del Rosso, J.Q.; Grada, A.; Bunick, C.G. Scientific Rationale and Clinical Basis for Clindamycin Use in the Treatment of Dermatologic Disease. Antibiotics 2024, 13, 270. [Google Scholar] [CrossRef]
- Tolentino, S.; Pereira, M.N.; Cunha-Filho, M.; Gratieri, T.; Gelfuso, G.M. Targeted Clindamycin Delivery to Pilosebaceous Units by Chitosan or Hyaluronic Acid Nanoparticles for Improved Topical Treatment of Acne Vulgaris. Carbohydr. Polym. 2021, 253, 117295. [Google Scholar] [CrossRef]
- Metwally, M.G.; Shehab, O.R.; Ibrahim, H.; El Nashar, R.M. Electrochemical Detection of Bisphenol A in Plastic Bottled Drinking Waters and Soft Drinks Based on Molecularly Imprinted Polymer. J. Environ. Chem. Eng. 2022, 10, 107699. [Google Scholar] [CrossRef]
- Shoman, N.A.; Saady, M.; Teaima, M.; Abdelmonem, R.; El-Nabarawi, M.A.; Elhabal, S.F. Merging Konjac Glucomannan with Other Copolymeric Hydrogels as a Cutting-Edge Liquid Raft System for Dual Delivery of Etoricoxib and Famotidine. Drug Deliv 2023, 30. [Google Scholar] [CrossRef]
- Ranjbar-Mohammadi, M.; Bahrami, S.H.; Joghataei, M.T. Fabrication of Novel Nanofiber Scaffolds from Gum Tragacanth/Poly(Vinyl Alcohol) for Wound Dressing Application: In Vitro Evaluation and Antibacterial Properties. Mater. Sci. Eng. C 2013, 33, 4935–4943. [Google Scholar] [CrossRef]
- Kamal Ahmed, R.; Saad, E.M.; Fahmy, H.M.; El Nashar, R.M. Design and Application of Molecularly Imprinted Polypyrrole/Platinum Nanoparticles Modified Platinum Sensor for the Electrochemical Detection of Vardenafil. Microchem. J. 2021, 171, 106771. [Google Scholar] [CrossRef]
- Rezaei, A.; Tavanai, H.; Nasirpour, A. Fabrication of Electrospun Almond Gum/PVA Nanofibers as a Thermostable Delivery System for Vanillin. Int. J. Biol. Macromol. 2016, 91, 536–543. [Google Scholar] [CrossRef] [PubMed]
- Zhou, Y.; Jia, W.; Bi, J.; Liu, M.; Liu, L.; Zhou, H.; Gu, G.; Chen, Z. Sulfated Hyaluronic Acid/Collagen-Based Biomimetic Hybrid Nanofiber Skin for Diabetic Wound Healing: Development and Preliminary Evaluation. Carbohydr. Polym. 2024, 334, 122025. [Google Scholar] [CrossRef]
- Parisi, O.I.; Ruffo, M.; Malivindi, R.; Vattimo, A.F.; Pezzi, V.; Puoci, F. Molecularly Imprinted Polymers (MIPs) as Theranostic Systems for Sunitinib Controlled Release and Self-Monitoring in Cancer Therapy. Pharmaceutics 2020, 12, 41. [Google Scholar] [CrossRef] [PubMed]
- Al-Shoubki, A.A.; Teaima, M.H.; Abdelmonem, R.; El-Nabarawi, M.A.; Elhabal, S.F. Potential Application of Sucrose Acetate Isobutyrate, and Glyceryl Monooleate for Nanonization and Bioavailability Enhancement of Rivaroxaban Tablets. Pharm. Sci. Adv. 2024, 2, 100015. [Google Scholar] [CrossRef]
- Thakur, S.; Anjum, M.M.; Jaiswal, S.; Kumar, A.; Deepak, P.; Anand, S.; Singh, S.; Rajinikanth, P.S. Novel Synergistic Approach: Tazarotene-Calcipotriol-Loaded-PVA/PVP-Nanofibers Incorporated in Hydrogel Film for Management and Treatment of Psoriasis. Mol. Pharm. 2023, 20, 997–1014. [Google Scholar] [CrossRef]
- Fallah-Darrehchi, M.; Zahedi, P.; Safarian, S.; Ghaffari-Bohlouli, P.; Aeinehvand, R. Conductive Conduit Based on Electrospun Poly (l-Lactide-Co-D, l-Lactide) Nanofibers Containing 4-Aminopyridine-Loaded Molecularly Imprinted Poly (Methacrylic Acid) Nanoparticles Used for Peripheral Nerve Regeneration. Int. J. Biol. Macromol. 2021, 190, 499–507. [Google Scholar] [CrossRef] [PubMed]
- Fathy Elhabal, S.; El-Nabarawi, M.A.; Abdelaal, N.; Elrefai, M.F.M.; Ghaffar, S.A.; Khalifa, M.M.; Mohie, P.M.; Waggas, D.S.; Hamdan, A.M.E.; Alshawwa, S.Z.; et al. Development of Canagliflozin Nanocrystals Sublingual Tablets in the Presence of Sodium Caprate Permeability Enhancer: Formulation Optimization, Characterization, in-Vitro, in Silico, and in-Vivo Study. Drug Deliv. 2023, 30, 2241665. [Google Scholar] [CrossRef]
- Elhabal, S.F.; Elwy, H.M.; Hassanin, S.; El-Rashedy, A.A.; Hamza, A.A.; Khasawneh, M.A. Biosynthesis and Characterization of Gold and Copper Nanoparticles from Salvadora persica Fruit Extracts and Their Biological Properties. Int. J. Nanomed. 2022, 17, 6095. [Google Scholar] [CrossRef]
- Saady, M.; Shoman, N.A.; Teaima, M.; Abdelmonem, R.; El-Nabarawi, M.A.; Elhabal, S.F. Fabrication of Gastro-Floating Sustained-Release Etoricoxib and Famotidine Tablets: Design, Optimization, in-Vitro, and in-Vivo Evaluation. Pharm. Dev. Technol. 2024, 29, 429–444. [Google Scholar] [CrossRef]
- Elhabal, S.F.; Ghaffar, S.A.; Hager, R.; Elzohairy, N.A.; Khalifa, M.M.; Mohie, P.M.; Gad, R.A.; Omar, N.N.; Elkomy, M.H.; Khasawneh, M.A.; et al. Development of Thermosensitive Hydrogel of Amphotericin-B and Lactoferrin Combination-Loaded PLGA-PEG-PEI Nanoparticles for Potential Eradication of Ocular Fungal Infections: In-Vitro, Ex-Vivo and in-Vivo Studies. Int. J. Pharm. X 2023, 5, 100174. [Google Scholar] [CrossRef] [PubMed]
- Abdelmonem, R.; Elhabal, S.F.; Abdelmalak, N.S.; El-Nabarawi, M.A.; Teaima, M.H. Formulation and Characterization of Acetazolamide/Carvedilol Niosomal Gel for Glaucoma Treatment: In Vitro, and In Vivo Study. Pharmaceutics 2021, 13, 221. [Google Scholar] [CrossRef] [PubMed]
- Mohammed, M.H.H.; Hamed, A.N.E.; Elhabal, S.F.; Mokhtar, F.A.; Abdelmohsen, U.R.; Fouad, M.A.; Kamel, M.S. Chemical Composition and Anti-Proliferative Activities of Hyophorbe lagenicaulis Aerial Parts and Their Biogenic Nanoparticles Supported by Network Pharmacology Study. S. Afr. J. Bot. 2023, 156, 398–410. [Google Scholar] [CrossRef]
- Al-Shoubki, A.A.; Teaima, M.H.; Abdelmonem, R.; El-Nabarawi, M.A.; Elhabal, S.F. Sucrose Acetate Isobutyrate (SAIB) and Glyceryl Monooleate (GMO) Hybrid Nanoparticles for Bioavailability Enhancement of Rivaroxaban: An Optimization Study. Pharm. Dev. Technol. 2023, 28, 928–938. [Google Scholar] [CrossRef] [PubMed]
- Nakatsuji, T.; Kao, M.C.; Fang, J.Y.; Zouboulis, C.C.; Zhang, L.; Gallo, R.L.; Huang, C.M. Antimicrobial Property of Lauric Acid against Propionibacterium Acnes: Its Therapeutic Potential for Inflammatory Acne Vulgaris. J. Investig. Dermatol. 2009, 129, 2480–2488. [Google Scholar] [CrossRef] [PubMed]
- Watanabe, T.; Hamada, K.; Tategaki, A.; Kishida, H.; Tanaka, H.; Kitano, M.; Miyamoto, T. Oral Administration of Lactic Acid Bacteria Isolated from Traditional South Asian Fermented Milk “dahi” Inhibits the Development of Atopic Dermatitis in NC/Nga Mice. J. Nutr. Sci. Vitaminol. 2009, 55, 271–278. [Google Scholar] [CrossRef] [PubMed]
- Theory and Practice of Histological Techniques, 4th ed.; Churchill Livingstone: Edinburgh, UK; London, UK; Melbourne, Australia; New York, NY, USA, 1996; Available online: https://www.google.com/search?q=Theory+and+practice+of+histological+techniques.+4th+Ed.+Churchill+Livingstone%2C+Edinburgh%2C+London%2C+Melbourne%2C+New+York.&rlz=1C1WOHY_enEG1087EG1087&oq=Theory+and+practice+of+histological+techniques.+4th+Ed.+Churchill+Livingstone%2C+Edinburgh%2C+London%2C+Melbourne%2C+New+York.&gs_lcrp=EgZjaHJvbWUyBggAEEUYOdIBCDQ4OTZqMGo0qAIIsAIB&sourceid=chrome&ie=UTF-8 (accessed on 9 April 2024).
- Yasser, M.; El Naggar, E.E.; Elfar, N.; Teaima, M.H.; El-Nabarawi, M.A.; Elhabal, S.F. Formulation, Optimization and Evaluation of Ocular Gel Containing Nebivolol Hcl-Loaded Ultradeformable Spanlastics Nanovesicles: In Vitro and in Vivo Studies. Int. J. Pharm. X 2024, 7, 100228. [Google Scholar] [CrossRef] [PubMed]
- Balcer, E.; Sobiech, M.; Luliński, P. Molecularly Imprinted Carriers for Diagnostics and Therapy—A Critical Appraisal. Pharmaceutics 2023, 15, 1647. [Google Scholar] [CrossRef] [PubMed]
- Sangnim, T.; Limmatvapirat, S.; Nunthanid, J.; Sriamornsak, P.; Sittikijyothin, W.; Wannachaiyasit, S.; Huanbutta, K. Design and Characterization of Clindamycin-Loaded Nanofiber Patches Composed of Polyvinyl Alcohol and Tamarind Seed Gum and Fabricated by Electrohydrodynamic Atomization. Asian J. Pharm. Sci. 2018, 13, 450–458. [Google Scholar] [CrossRef] [PubMed]
- Mohammed, M.H.H.; Hamed, A.N.E.; Elhabal, S.F.; Mokhtar, F.A.; Abdelmohsen, U.R.; Fouad, M.A.; Kamel, M.S. Metabolic Profiling and Cytotoxic Activities of Ethanol Extract of Dypsis Leptocheilos Aerial Parts and Its Green Synthesized Silver Nanoparticles Supported by Network Pharmacology Analysis. S. Afr. J. Bot. 2023, 161, 648–665. [Google Scholar] [CrossRef]
- Toudeshki, R.M.; Dadfarnia, S.; Haji Shabani, A.M. Surface Molecularly Imprinted Polymer on Magnetic Multi-Walled Carbon Nanotubes for Selective Recognition and Preconcentration of Metformin in Biological Fluids Prior to Its Sensitive Chemiluminescence Determination: Central Composite Design Optimization. Anal. Chim. Acta 2019, 1089, 78–89. [Google Scholar] [CrossRef] [PubMed]
- El-Nawawy, T.M.; Adel, Y.; Teaima, M.; Nassar, N.; Nemr, A.; Al-Samadi, I.; El-Nabarawi, M.A.; Elhabal, S. Intranasal Bilosomes in Thermosensitive Hydrogel: Advancing Desvenlafaxine Succinate Delivery for Depression Management. Pharm. Dev. Technol. 2024, 29, 1–36. [Google Scholar] [CrossRef] [PubMed]
- Parisi, O.I.; Ruffo, M.; Scrivano, L.; Malivindi, R.; Vassallo, A.; Puoci, F. Smart Bandage Based on Molecularly Imprinted Polymers (MIPs) for Diclofenac Controlled Release. Pharmaceuticals 2018, 11, 92. [Google Scholar] [CrossRef] [PubMed]
- Kang, M.S.; Cho, E.; Choi, H.E.; Amri, C.; Lee, J.H.; Kim, K.S. Molecularly Imprinted Polymers (MIPs): Emerging Biomaterials for Cancer Theragnostic Applications. Biomater. Res. 2023, 27, 45. [Google Scholar] [CrossRef]
- Lee, S.J.; Heo, D.N.; Moon, J.H.; Park, H.N.; Ko, W.K.; Bae, M.S.; Lee, J.B.; Park, S.W.; Kim, E.C.; Lee, C.H.; et al. Chitosan/Polyurethane Blended Fiber Sheets Containing Silver Sulfadiazine for Use as an Antimicrobial Wound Dressing. J. Nanosci. Nanotechnol. 2014, 14, 7488–7494. [Google Scholar] [CrossRef] [PubMed]
- Khalil, M.; Hashmi, U.; Riaz, R.; Rukh Abbas, S. Chitosan Coated Liposomes (CCL) Containing Triamcinolone Acetonide for Sustained Delivery: A Potential Topical Treatment for Posterior Segment Diseases. Int. J. Biol. Macromol. 2020, 143, 483–491. [Google Scholar] [CrossRef]
- Zaklan, D.; Nešić, D.; Mitrović, D.; Lazarević, S.; Đanić, M.; Mikov, M.; Pavlović, N. Influence of Bile Acids on Clindamycin Hydrochloride Skin Permeability: In Vitro and In Silico Preliminary Study. Eur. J. Drug Metab. Pharmacokinet. 2024, 49, 219–228. [Google Scholar] [CrossRef]
- Hamza, A.A.; Khasawneh, M.A.; Elwy, H.M.; Hassanin, S.O.; Elhabal, S.F.; Fawzi, N.M. Salvadora Persica Attenuates DMBA-Induced Mammary Cancer through Downregulation Oxidative Stress, Estrogen Receptor Expression and Proliferation and Augmenting Apoptosis. Biomed. Pharmacother. 2022, 147, 112666. [Google Scholar] [CrossRef]
- El-Gizawy, S.A.; Osman, M.A.; Ibrahim, S.F. Effect of Cosolvents on the Absorptive Clearance of Ketotifen Fumarate from Rabbit Intestine, In-Situ. J. Adv. Pharm. Res. 2018, 2, 168–179. [Google Scholar] [CrossRef][Green Version]
- Iturrioz-Rodríguez, N.; Sampron, N.; Matheu, A. Current Advances in Temozolomide Encapsulation for the Enhancement of Glioblastoma Treatment. Theranostics 2023, 13, 2734–2756. [Google Scholar] [CrossRef]
- Abdelfattah, D.S.E.; Fouad, M.A.; Elmeshad, A.N.; El-Nabarawi, M.A.; Elhabal, S.F. Anti-Obesity Effect of Combining White Kidney Bean Extract, Propolis Ethanolic Extract and CrPi3 on Sprague-Dawley Rats Fed a High-Fat Diet. Nutrients 2024, 16, 310. [Google Scholar] [CrossRef] [PubMed]

| a | |||||||||
| Sample | Clindamycin Template (mg) | MAA (mmol) | AIBN (mg) | EGDMA (mmol) | Particle Size (nm) | Polydispersity Index (PdI) | |||
| NIP 1 | 0 | 2 | 150 | 10 | 84 | 0.56 | |||
| NIP 2 | 0 | 4 | 150 | 20 | 45 | 0.51 | |||
| MIP 1 | 424.98 | 2 | 150 | 10 | 150 | 0.44 | |||
| MIP2 | 424.98 | 4 | 150 | 20 | 110 | 0.49 | |||
| b | |||||||||
| Ci (mol/L) | Bound Clin (%) | Bound Lin (%) | α Clin | α Lin | ε | ||||
| MIP | NIP | MIP | NIP | ||||||
| 0.25 | 48 ± 0.31 | 39 ± 0.61 | 18 ± 0.30 | 17 ± 0.60 | 1.23 | 1.06 | 2.67 | ||
| 0.5 | 59 ± 0.61 | 43 ± 0.31 | 20 ± 0.60 | 18 ± 0.30 | 1.37 | 1.11 | 2.95 | ||
| 0.75 | 67 ± 0.21 | 49 ± 0.12 | 24 ± 0.20 | 21 ± 0.10 | 1.37 | 1.14 | 2.79 | ||
| 1 | 79 ± 0.21 | 51 ± 0.01 | 26 ± 0.20 | 22 ± 0.01 | 1.55 | 1.18 | 3.04 | ||
| 1.25 | 78 ± 0.21 | 57 ± 0.01 | 31 ± 0.20 | 29 ± 0.01 | 1.37 | 1.07 | 2.52 | ||
| c | |||||||||
| Polymer | High-Affinity Sites | Low-Affinity Sites | |||||||
| Ka (M−1) | Bmax (mM/g) | R2 | Ka (M−1) | Bmax (mM/g) | R2 | ||||
| MIP | 0.7347 | 0.1123 | 0.933 | 0.0891 | 0.1642 | 0.8845 | |||
| NIP | 0.1469 | 0.0197 | 0.9495 | ||||||
| d | |||||||||
| Polymer | Pseudo-First Order | Pseudo-Second Order | |||||||
| Qe (mol/g) | K1 (h−1) | R2 | Qe (g/mol/h) | K2 (h−1) | R2 | ||||
| MIP | 0.0003286 | 0.1309 | 0.9994 | −3.718 × 10−6 | 6.42 × 1011 | 0.9842 | |||
| NIP | 0.0007199 | 0.0181 | 0.9995 | 4.06 × 109 | −0.000806 | 0.9885 | |||
| Formulation | Weight Uniformity (mg) | Thickness (mm) | Folding Endurance (Times) | Tensile Strength (MPa) |
|---|---|---|---|---|
| Clin-MIP-polyurethane nanofiber | 31.54 ± 0.1 | 0.28 ± 0.01 | 174 ± 3 | 1.82 ± 0.03 |
| polyurethane nanofiber | 22.65 ± 0.2 | 0.18 ± 0.01 | 154 ± 5 | 1.99 ± 0.02 |
| Formula | Jss (µg/cm2/h) | Kp (cm/h) | Q24 (µg/cm2) | Skin Deposition (µg/cm2) |
|---|---|---|---|---|
| Clin suspension | 15 ± 0.21 | 1.5 ± 0.11 | 450 ± 0.43 | 123.75 ± 0.64 |
| Clin-MIP | 12.78 ± 0.32 | 1.28 ± 0.42 | 620 ± 0.45 | 169.75 ± 0.55 |
| Clin-MIP polyurethane nanofiber | 19.44 ± 0.33 | 0.6075 ± 0.41 | 830 ± 0.13 | 171.015 ± 0.23 |
| Bacterial Strains | Clindamycin (Blank) | Clin-MIP Polyurethane Nanofiber | ||
|---|---|---|---|---|
| MIC (μg/mL) | MBC (μg/mL) | MIC (μg/mL) | MBC (μg/mL) | |
| Staphylococcus epidermidis (ATCC 12228) | 12.5 ± 0.2 | 12.5 | 6.25 ± 1.8 | 6.25 |
| Staphylococcus aureus (ATCC 6538) | 3.125 ± 0.9 | 6.25 | 0.39 ± 0.2 | 0.39 |
| Streptococcus mutans ATCC 25175 | 3.125 ± 0.9 | 12.5 | 0.78 ± 1.3 | 3.125 |
| Klebsiella pneumoniae (ATCC13883) | NA | NA | 1.56 ± 0.9 | 3.9 |
| Pseudomonas aeruginosa (ATCC90274) | NA | NA | 6.25 ± 0 | 6.25 |
| Proteus vulgaris (ATCC13315) | NA | NA | 1.56 ± 0.45 | 3.9 |
| Groups | Left F1 | Right F1 | Left F2 | Right F2 | Left F3 | Right F3 | ||||||||||||
|---|---|---|---|---|---|---|---|---|---|---|---|---|---|---|---|---|---|---|
| Number of examined fields | 10 | 10 | 10 | 10 | 10 | 10 | ||||||||||||
| Grade | - | + | - | + | - | + | - | + | ++ | - | + | ++ | - | + | ++ | - | + | ++ |
| Abnormal changes | ||||||||||||||||||
| Hyperkeratosis | 5 | 0 | 5 | 6 | 3 | 1 | 2 | 5 | 3 | 4 | 4 | 2 | 3 | 5 | 2 | 7 | 3 | 0 |
| Inflammatory cells infiltration | 2 | 6 | 2 | 4 | 6 | 0 | 1 | 5 | 4 | 2 | 8 | 0 | 1 | 7 | 2 | 4 | 6 | 0 |
| Thick epidermis (hypertrophy) | 6 | 1 | 3 | 9 | 1 | 0 | 4 | 3 | 3 | 8 | 2 | 0 | 4 | 1 | 5 | 9 | 1 | 0 |
| Dermal congestion | 5 | 3 | 2 | 8 | 2 | 0 | 4 | 3 | 3 | 7 | 3 | 0 | 4 | 3 | 3 | 9 | 1 | 0 |
Disclaimer/Publisher’s Note: The statements, opinions and data contained in all publications are solely those of the individual author(s) and contributor(s) and not of MDPI and/or the editor(s). MDPI and/or the editor(s) disclaim responsibility for any injury to people or property resulting from any ideas, methods, instructions or products referred to in the content. |
© 2024 by the authors. Licensee MDPI, Basel, Switzerland. This article is an open access article distributed under the terms and conditions of the Creative Commons Attribution (CC BY) license (https://creativecommons.org/licenses/by/4.0/).
Share and Cite
Elhabal, S.F.; Abdelmonem, R.; El Nashar, R.M.; Elrefai, M.F.M.; Hamdan, A.M.E.; Safwat, N.A.; Shoela, M.S.; Hassan, F.E.; Rizk, A.; Kabil, S.L.; et al. Enhanced Antibacterial Activity of Clindamycin Using Molecularly Imprinted Polymer Nanoparticles Loaded with Polyurethane Nanofibrous Scaffolds for the Treatment of Acne Vulgaris. Pharmaceutics 2024, 16, 947. https://doi.org/10.3390/pharmaceutics16070947
Elhabal SF, Abdelmonem R, El Nashar RM, Elrefai MFM, Hamdan AME, Safwat NA, Shoela MS, Hassan FE, Rizk A, Kabil SL, et al. Enhanced Antibacterial Activity of Clindamycin Using Molecularly Imprinted Polymer Nanoparticles Loaded with Polyurethane Nanofibrous Scaffolds for the Treatment of Acne Vulgaris. Pharmaceutics. 2024; 16(7):947. https://doi.org/10.3390/pharmaceutics16070947
Chicago/Turabian StyleElhabal, Sammar Fathy, Rehab Abdelmonem, Rasha Mohamed El Nashar, Mohamed Fathi Mohamed Elrefai, Ahmed Mohsen Elsaid Hamdan, Nesreen A. Safwat, Mai S. Shoela, Fatma E. Hassan, Amira Rizk, Soad L. Kabil, and et al. 2024. "Enhanced Antibacterial Activity of Clindamycin Using Molecularly Imprinted Polymer Nanoparticles Loaded with Polyurethane Nanofibrous Scaffolds for the Treatment of Acne Vulgaris" Pharmaceutics 16, no. 7: 947. https://doi.org/10.3390/pharmaceutics16070947
APA StyleElhabal, S. F., Abdelmonem, R., El Nashar, R. M., Elrefai, M. F. M., Hamdan, A. M. E., Safwat, N. A., Shoela, M. S., Hassan, F. E., Rizk, A., Kabil, S. L., El-Nabarawy, N. A., Taha, A. A., & El-Nabarawi, M. (2024). Enhanced Antibacterial Activity of Clindamycin Using Molecularly Imprinted Polymer Nanoparticles Loaded with Polyurethane Nanofibrous Scaffolds for the Treatment of Acne Vulgaris. Pharmaceutics, 16(7), 947. https://doi.org/10.3390/pharmaceutics16070947

